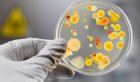

Ситуация с массовым заболеванием сальмонеллезом в детском саду № 62 города Иркутска набирает обороты. Число жертв инфекции выросло с 21 до 24 человек ...
Небольшое ЧП произошло в минувшую субботу на Восточно-Сибирской железной дороге: около семи часов вечера на перегоне Дзелинда – Кирон с рельсов сошла ...
Страшная трагедия произошла в прошедшие выходные в Нижнеудинском районе. Маленький мальчик покончил жизнь самоубийством.Полицейские полностью ...
Троих участников дорожно-транспортного происшествия накануне спасли сотрудники МЧС от возможной гибели. Авария произошла вчера вечером на объездной в ...
Крупную партию природного золота изъяли накануне у жителей Бодайбинского района. 10 килограммов драгоценного металла хранилось более полугода в ...
Сотрудники полиции Иркутского района разыскивают годовалую малышку. Сообщение о пропаже девочки в поселке Никола поступило накануне. По словам ...
Спасателям удалось связаться с двумя рыбаками, об исчезновении которых сообщили их родственники. С заявление о пропаже супруга в Байкальский ...
В деле о пропаже маленькой девочки в Иркутском районе появились новые, страшные подробности: мать ребенка призналась, что сама год назад закопала ...
В Слюдянском районе полиция пресекла незаконную перевозку автомобильным транспортом более 40 тонн партии фальсифицированной спиртосодержащей ...
В грядущий четверг, 31 января, жителям Иркутска и Ангарска не стоит беспокоиться, едва заслышав тревожный вой сирен. В двух городах нашего региона ...
Во избежание схода снежных лавин на горных склонах Приангарья начались первые в этом году профилактические обстрелы. Накануне были проведены взрывные ...
В городе Усть-Илимске из-за недосмотра родителей вчера пострадал маленький мальчик. 5-летний ребенок, оставленный дома без присмотра, выпал из окна ...
Сегодня ночью в Иркутске неизвестные злоумышленники попытались пробраться в помещение общественной приемной председателя городской Думы Андрея ...
Полиция проводит проверку по факту столкновения иномарки и служебного автомобиля.Как сообщает пресс-служба ГУ МВД России по Иркутской области, авария ...
Сообщение о начавшихся родах у жительницы пос. Листвянка поступило дежурному Байкальского поисково-спасательного отряда МЧС России по Иркутской ...
Авария произошла днем 13 декабря в Свердловском округе Иркутска на улице Захарова. По предварительным данным, водитель троллейбуса не уступил дорогу автомобилю Toyota Caldina, что привело к столкновению, как сообщает пресс-служба ГУ МВД России по Иркутской области.